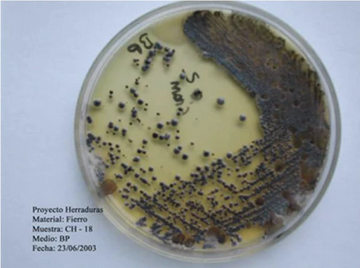
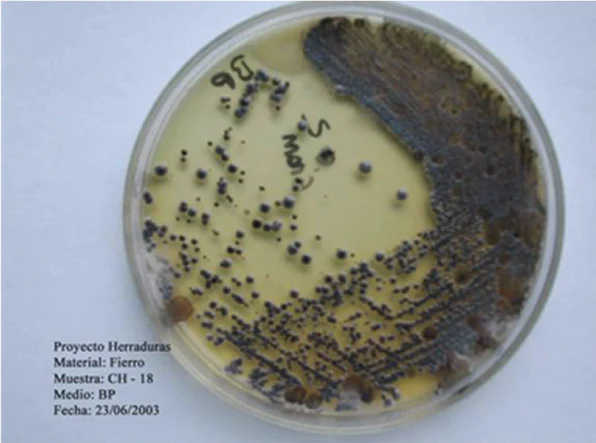
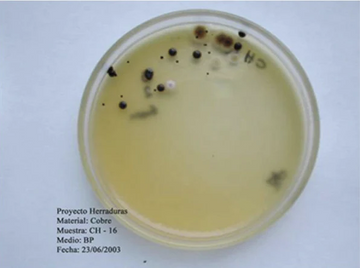

Farrier's Corner
Kawell USA began as a project to develop products based on copper to take advantage of its antimicrobial properties and its benefits in providing solutions to diseases associated with bacteria and fungi.
Through research and several case studies, Kawell USA has developed proven copper alloy horseshoe and inserts to help improve hoof health and the overall quality of a horse's hoof.
Below you can find the research, results, and examples of our work. Our horseshoes and inserts are a patent design and are certified by the Environmental Protection Agency.
The institutions involved in this research were the Center for the Investigation, Development and Innovation of Structures and Materials (IDIEM) and the Institute of Nutrition and Food Technology (INTA), both under the authority of the University of Chile and University Santiago of Chile, Center of the Investigation of Materials. The department of Farriership of the Faculty of Veterinary and Animal Sciences of the University of Chile supported and consulted the whole investigation.
Environmental Protection Agency
In order for a copper alloy company to make any claims about antibacterial properties, they must undergo testing and registration with the EPA.
To date, Kawell USA is the only horseshoe company registered with the Environmental Protection Agency.
(EPA) # 82012-3 Patent # US 9 107 398 B2
Copper Development Association UNS Alloy
No. C6915


How Does Copper Kill Bacteria
Copper is naturally antibacterial and antifungal, and can kill bacteria by direct contact. EPA approved horseshoes have a 99.9% effectiveness against killing bacteria that comes into contact with the shoe.
Copper kills bacteria through a natural process that occurs when it interacts with water and salts in the environment—such as sweat, urine, or the damp conditions of a horse's hoof. This interaction causes copper salts to be released, that disrupt bacterial and fungal cell walls, interfere with their metabolism, and ultimately lead to cell death. This antimicrobial effect creates an inhospitable environment where bacteria and fungi cannot survive or reproduce.

Shock Absorption
Studies at the University of Santiago Chile (USACH) show that by using Kawell USA copper alloy horseshoes, the reaction force decreases by 8.56%. This transmits less force and power up through the horse limb, decreasing shock to the the bones, ligaments, joints, and tendons compared to steel horseshoes.

Durability
Kawell USA Copper Alloy Horseshoes can be worked in hot or cold, and requires less time and temperature in the forage (maximum temp 840°F o 450°C). They have a similar durability to steel shoes, and can be used for multiple sets.
Research Behind Our Work
We are constantly testing our designs and concepts through real world trials and research studies in order to keep providing you with products that you can rely on to do the job.
We can see two mediums containing our copper alloy on the left and another of a more traditional iron allow on the right. These are take after two weeks in a BP medium to testing to Staphylococcus and other bacteria.
The same antimicrobial properties have been preserved and carried over to our line of hoof pastes.
Using copper alloy helps protect against 99% of disease-causing bacteria
Copper helps reduce impact-shock by up to 8.53% per step. Kawell USA Copper Alloy is 100% recyclable.
Common Questions
What makes copper alloy antimicrobial, and how does it work?
Kawell's Copper Alloy is naturally antimicrobial due to it's ability to release copper salts when exposed to moisture, oxygen, and salts in the environment. These copper salts are toxic to a wide range of microorganisms, including bacteria, fungi, and some viruses. When microbes come into contact with a copper alloy surface, the copper salts penetrate their cell walls, disrupt their metabolic processes, and damage their DNA and proteins. This multi-targeted attack overwhelms the organism, causing rapid cell death and preventing replication. Unlike chemical disinfectants, copper alloy's antimicrobial action is continuous and doesn’t rely on active application, making Kawell's Copper Alloy an effective and long-lasting solution for reducing microbial contamination.
What kind of horse can benefit from the use of copper-alloy horseshoes?
Any horse that has problems resulting from bacterial or fungal infections, such as thrush, white line disease and chronic abscesses, which can be especially prevalent in wet or humid climates, or in situations where the conditions in which the horse is kept make the horse susceptible to these problems. In addition, due to the shock absorption qualities of the shoes, any horse that can benefit from minimizing shock to the feet legs, such as endurance horses and horses ridden on hard surfaces, such as concrete or asphalt pavement. Endurance horses that have used these shoes in events have been shown to have little to no leg swelling (stocking up) and soreness after the event, and their race times have shown considerable improvements when compared to wearing steel shoes.
Do the copper-alloy shoes require any special handling when shaping or modifying?
The shoes can be worked either cold or hot. When shaped cold, they should work like steel shoes, which a bit more "spring" when hit with the hammer. If used in hot shoeing, they should be treated like aluminum and not heated more than app. 900 degrees (half a heat) or they will fall apart. If not overheated, they will work fine.
Copper is a soft metal, will these shoes hold up?
These shoes are a copper alloy, consisting of app. 84% copper along with 5 other metals resulting from quite a few years of development. This unique combination allows for the shoes to wear similarly to a steel shoe while retaining the antimicrobial properties in copper. In many cases, the shoes can be reset 1-2 times.
What type of nails do you use the Kawell USA horseshoe with?
Steel nails.